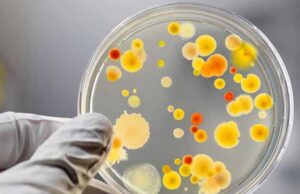
Класична відписка Класична відписка

admin
Під Сіверодонецьком загинув ще один боєць із Волині
3-го жовтня стало відомо про загибель 32-річного бійця 24-ї механізованої бригади Віктора Рупи, уродженця села Хренів, Іваничівського району, - пише «БУГ».Віктор Рупа був...
У неділю відбудеться відкритий чемпіонат м. Нововолинська з тхеквондо-ВТФ
9 жовтня, о 12:00, у міському Палаці спорту відбудуться змагання з тхеквондо-ВТФ серед дітей, молодших юнаків, юнаків, кадетів та юніорів. Змагатись будуть спортсмени із...
ДП “Волиньвугілля” хочуть реорганізувати
Новий генеральний директор ДП «Волиньвугілля» може одночасно стати очільником нововолинської шахти №10. Щодо розвитку шахти, то планують розробку інвестиційного проекту та створення на її...
Класична відписка
Надійшла на мій інформаційний запит від во начальника Нововолинського управління Держпроспоживслужби Я.Ю. Лешка. На філію якого покладені обов’язки контролю за санітарно-епідеміологічною ситуацією у нашому...
СБУ блокувала перемогу в тендері шахти № 10 «Нововолинська» фірм з...
На Волині співробітники Служби безпеки України блокували перемогу у тендері комерційних структур з російським капіталом.
У серпні цього року державне підприємство «Передпускова дирекція шахти №...
СБУ на Волині попередила контрабанду рідкісних книг
Співробітники СБУ на митному посту «Ягодин» виявили та вилучили у громадянина Німеччини збірку рідкісних книг. Зловмисник намагався незаконно вивезти з України у багажнику власного...
На зупинці 9-ї шахти фура врізалася в автобус з шахтарями!
В 15:10, на зупинці шахти № 9 «Нововолинська», фура зіткнулася із пасажирським автобусом, який здійснював висадку пасажирів.З тілесними ушкодженнями госпіталізовано декілька пасажирів.
Запрошую всіх небайдужих на 2-й судовий процес до міського голови Нововолинська...
Всіх небайдужих нововолинців, інших волинян, на 2-й судовий адміністративний процес – відповідно мого позову до міського голови м. Нововолинська Віктора Сапожнікова, першого заступника міського...
Нововолинські посадовці купують товари за завищеними цінами
Нововолинський міський голова не вжив заходів щодо посадовців, які допустили перевитрати бюджетних коштів під час закупівлі обладнання.Про це йшлося під час оперативної наради в...
Вбивство Каті Литкіної розслідували журналісти “Говорить Україна” (оновлено)
У понеділок 26.09 о 19.45 на каналі ТРК УКРАЇНА в програмі "Говорить Україна" було проведено журналістське розслідування звірячого вбивства неповнолітньої Каті Литкіної.
Проблема скорочення ліжко-місць у Нововолинській міській лікарні
"Отже проблему скорочення ліжко-місць у Нововолинській міській лікарні нарешті визнали офіційно і дуже тихо, тобто без обговорення з місцевим населенням", - пише у фейсбук...
На виклик через пограбування поліція їхала півгодини
Про почуття спустошеності церез вкрадені з квартири цінності та неквапливу реакцію поліції в соцмережі розповідає Катерина Ніверська:"Який рідний не був б Нововолинськ, але житти...
Поліція шукає мешканця Нововолинська, який пішов з дому та по даний...
16.09.2016 року громадянин Турдукеєв Акілбек Мамакович, 10.05.49 р.н., н/п, жит. м. Нововолинськ, пішов з дому та по даний час не повернувся.В разі отримання інформації...
На Волині взято під варту двох пропагандистів «русского міра»
За клопотанням слідчих СБУ на Волині взято під варту двох пропагандистів «руського міра». Один з них – безробітний, раніше засуджений 33-річний мешканець Нововолинська, створив...
Працівникам ВУКГ, які ремонтували зупинку, не вистачило… двох дошок)
Володимир Власюк у фейсбук: "Пам’ятаєте, я влітку ініціював звернення до міського голови Віктора Сапожнікова із закликом навести лад із зупинкою громадського транспорту, що на...
Через тиждень часу ПП «Екопротеїн» будемо закривати силою, – Ігор Гузь
У понеділок, о 9:30, небайдужі жителі міста, народний депутат України Ігор Гузь, депутати Нововолинської міської ради, а також представники санепідемстанції інспектували приватне підприємство «Екопротеїн»,...
У Луцьку з ізолятора втік затриманий, взявши заручників!
Вчора вночі втік затриманий, якого правоохоронці тримали у Луцьку під вартою. Оскільки чоловік наніс собі тілесні ушкодження (ковтав гострі предмети), його доставили у міську...
Поліція затримала “мінера” маркету “Вопак”
Сьогодні, 14 вересня о 13:00 на лінію екстреного виклику поліції «102» зателефонував чоловік, який повідомив, що він замінував один із супермаркетів у місті Нововолинськ....
Надійшов дзвінок від аноніма про мінування супермаркету «Вопак»
Дорогу і територію в центрі по проспекту Перемоги перекрили. Мешканців будинку, де розташований «Вопак», та відвідувачів торгового центру, що на першому поверсі даного будинку...
СБУ повідомила про підозру нововолинцю у посяганні на територіальну цілісність України
Двох волинян із Луцька та Нововолинська підозрюють у розпалюванні національної ворожнечі та ненависті. Про це повідомили у прес-службі прокуратури Волинської області.Прокуратура Волинської області...